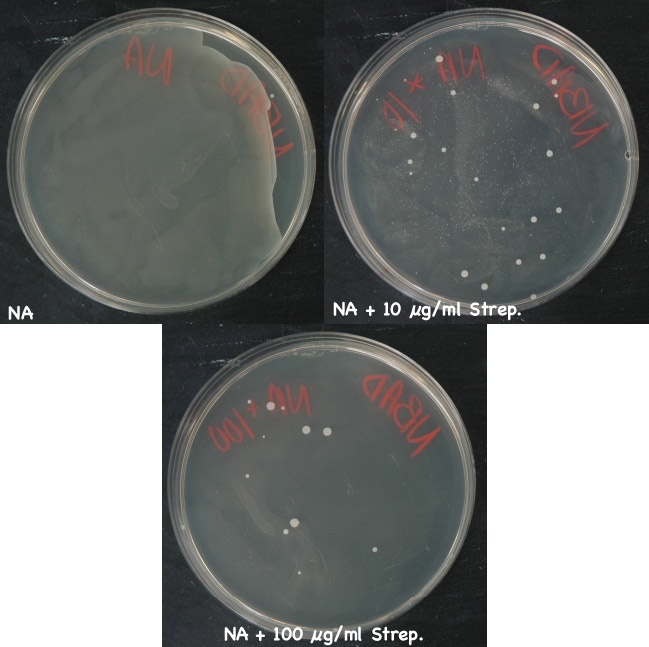

Evidentemente…tanti anni fa: la streptomicina e il primo studio randomizzato
UO di Pediatria Ospedale San Giacomo Castelfranco Veneto (TV)
Indirizzo per corrispondenza: dradzik@tiscali.it

Figura
1. Robert Koch
Il Comitato, presieduto dall'illustre clinico (era stato uno dei medici di Churchill), decise allora di avviare una serie di trial multicentrici da condursi nelle Unità di Cura contro la tubercolosi in alcune città del Regno Unito. Stava per essere realizzato il primo Studio Clinico Randomizzato. L'idea era quella di arruolare pazienti di età compresa fra 15 e 30 anni con “tubercolosi polmonare bilaterale progressiva, di recente insorgenza, dimostrata con l'esame batteriologico e per la quale non si riteneva opportuna la collasso terapia”.

Figura
2. Il prestigioso Brompton Hospital
Figura
3.
Gli investigatori non erano a conoscenza (“ciechi”) del gruppo di trattamento assegnato ai partecipanti, così come i pazienti non sapevano di essere stati inseriti in uno studio: essi venivano seguiti regolarmente con controlli clinici ed effettuavano mensilmente un Rx torace, un esame batteriologico dell'escreato e gli esami del sangue.
La streptomicina dimostrò di essere efficace: durante i primi 6 mesi di terapia 4 pazienti su 55 in trattamento attivo morirono, contro 15 su 52 tra quelli che erano stati sottoposti al solo riposo a letto (Tabella). Una nuova era nella lotta contro la tbc stava per nascere, anche se nei successivi 6 mesi la differenza fra i due gruppi era quasi scomparsa (ci furono 8 morti nel gruppo streptomicina e 9 in quello di controllo). I bacilli erano diventati resistenti al nuovo farmaco.
| Esito | Streptomicina | Controllo | RRR (IC 95%) | NNT |
|---|---|---|---|---|
| Mortalità | 7% | 29% | 75% (da 29 a 91) | 5 (da 3 a 14) |
Mortalità | 7% | 29% | 75% |
5 (da 3 a 14)
Tabella 1. Efficacia della streptomicina vs. riposo a letto dopo 6 mesi di trattamento
Abbreviazioni: RRR = Riduzione Relativa del Rischio con IC 95% (Intervalli di Confidenza al 95%), NNT = Number Needed To Treat calcolati dai dati dell'articolo con il Programma Confidence Interval Analysis vers 2.1.1.
Grazie a questo primo trial1 si ottennero numerose informazioni su quale doveva essere il miglior trattamento contro la tbc: una nuova formidabile arma era disponibile, ma doveva venir somministrata insieme ad un altro medicinale, che sarebbe stato usato da lì a poco, l'acido para-aminosalicilico (PAS), allo scopo di ridurre l'insorgere dell'antibiotico resistenza. Vennero anche segnalati alcuni effetti tossici legati all'uso della streptomicina, di cui quello sull'orecchio interno risultò essere il più importante.
Grande fu la soddisfazione di tutto il mondo scientifico nell'apprendere simili risultati. Da allora il disegno di questo trial, eseguito in maniera così brillante, divenne punto di riferimento per gli studi futuri.
Per chi desidera continuare il viaggio...nella storia della medicina si consiglia la navigazione nel sito web:www.jameslindlibrary.org
Daniels M, Hill AB. Chemotherapy of pulmonary tubercolosis in young adults; an analysis of the combined results of three Medical Research Council Trials. BMJ 1952;1:1162-68.
Bibliografia
